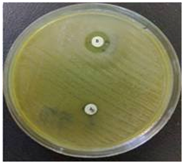

Now You Know Medical Textile Wound Care (Part-2)
Tuesday, 22 January 2019
Edit
MEDI-TEX WOUND CARE (PART-2)
1Deepalakshmi.K,1deepatextile29@gmail.com,
Textile Technology,
Jaya Engineering College, Chennai, India.
2Rajan.S,2srajusri123@gmail.com, Textile Chemistry,
SSM College of Engineering, Namakkal, India.
Textile Technology,
Jaya Engineering College, Chennai, India.
2Rajan.S,2srajusri123@gmail.com, Textile Chemistry,
SSM College of Engineering, Namakkal, India.
RESULTS AND DISCUSSION
FT-IR Test Result
![]() |
| Fig 5: FTIR Spectra |
The other compounds which also influence the property of antibacterial effect which also ranges in the desired frequency. The table below shows the frequency range of mimosa functional compounds.
S.NO | Range | Functional Group |
1 | 1558-1667 | Alkaloids |
2 | 1200-920 | Glycosides |
3 | 2800 | Carbohydrates |
4 | 470-490 | Proteins |
5 | 895 | Steroids |
6 | 1600-3300 | Flavonoids |
7 | 2900 | Phenols |
Table I: FTIR Frequency Range Values
SEM Test Result
It can be used to examine micro fabric and crystallographic orientation in many materials.
![]() |
| Fig 6: SEM of Medicated Herbal Bandage coated with Mimosa Pudica extract |
![]() |
| Fig 7 a:Untreated gauze |
![]() |
| Fig 7 b: Treated gauze |
A well absorbent fabric behaves like a wick and water rises through it against gravity. If the water is tinted with dye, the height of the water level wicked through the fabric strip can be noted. Wicking height is higher for a good absorbent fabric. So the below table shows the wicking behaviour of both treated and untreated sample.
SAMPLES | UNTREATED | TREATED |
1 | 15 | 18 |
2 | 14 | 16.5 |
3 | 15.5 | 18.5 |
4 | 14.5 | 16 |
5 | 15 | 16.5 |
Average | 14.8 (cm) | 17.5 (cm) |
Table II: Absorbency Test Values
The above test is carried for 15 mints for each sample.
For 1 mint the absorbency of treated sample is 8cm
For 5 mints the absorbency of treated sample is 12cm
For 10 mints the absorbency of treated sample is 14cm
The above results show that the treated sample has high absorbency than the untreated sample. Thus the wicking behaviour is high for treated sample. Tests were also carried out for 1 min, 5 min, 10 mints , the absorbency rate decreasing due to the gravity because at the higher wicking height the influence of gravity is higher, therefore lowering the absorption of water.
Phytochemical Test Result
Phytochemical screening of the plant extract was carried to find the presence of phyto compounds present in the extract. To identify the phytochemicals in plant extract chemical tests were carried out.
Test For Saponins
To 1 ml of extract 5 ml of distilled water was added and shaken vigorously. Observed for foam appearance indicates the presence of saponins.
![]() |
| Fig 8: Foam indicates Saponins |
To 1 ml of extract 5 ml of dilute ammonia solution was added, followed by addition of concentrated sulphuric acid along the sides of the tube. Appearance of yellow colouration.
![]() |
| Fig 9: Yellow indicates Flavonoids |
1 ml of sample was taken to that few drops of Dragandoff reagent was added and observed for orange red colour.
![]() |
| Fig 10: Red Orange Indicates Alkaloids |
1 ml of the filtrate was taken to that 10% concentration H2SO4 was added and observed for green colour.
![]() |
| Fig 11: Green Indicates Steroids |
The sample of cotton gauze is inoculated in the culture plates containing bacteria of staphylococcus aureus and kiebsiella pneumonia. Based on the bacterial growth on nutrient agar plates after 24 hours of incubation with the test specimen, the sample cotton gauze is found to have antibacterial activity as there was a zone of inhibition against the test organisms. As per standard, the fabric material will be considered to have antibacterial activity only when there is no bacterial growth directly under the sample in the contact area.
![]() |
| Fig 12: Zone of Inhibition |
Sample | Bacteriostatic activity in mm | Growth under fabric | |
Staphylococcus Aureus AATCC 6538 | Klebsiella Pneumonia AATCC 4352 | ||
Cotton Gauze | 13mm | 17mm | Nil |
Table III: Antibacterial Test Result- Zone of Inhibition
Test Summary:
Technique used : Direct inoculation, Well Diffusion Method
Amount of sample taken: 5*2.5 cm for each bacterium
Incubation Period : 37 degree Celsius for 24 – 48 hours
WOUND HEALING TEST REPORT
The Mimosa Pudica ethanol extract shows very good wound healing activity. The ethanol herbal extract exhibited good wound healing activity probably due to the presence of phenols constituents.
![]() |
| Fig 13: Albino Rat |
![]() |
| Fig 14: Wound Inflicted on Rat |
![]() |
| Fig 15: Medicated Herbal Bandage |
![]() |
| Fig 16: Wound Contraction in 5 Wound days |
Wound contraction was monitored by metric measurement of the wound area. This was studied by tracing the raw wound area on a transparent polythene paper and the traced area was measured by using a graph paper. The wound contraction was measured as a percentage decrease of original wound size of 500mm2 for each animal of a group.
Results were expressed as mean ± SEM. The data were analysed by using one way analysis of variance (ANOVA) followed by Dunnet’s test. P values<0.05 were considered as significant.
Groups | Drug Treatment | Wound Contraction(days) | ||
1 | 4 | 7 | ||
I | Control(Non Medicated Gauze) | 16.17 ±0.70 | 35.67 ±0.34 | 87.07 ±1.67 |
II | Test Control (Medicated Gauze) | 16.88 ±0.70 | 167.56 ±1.67*** | 234.98 ±12.98*** |
Table IV: Effect of Medicated Herbal Bandage on Wound Contraction
Values are in Mean ± SEM; (n=6), *P<0.05, **P<0.01, ***P<0.001 Vs. Control.
Wound Healing Activity on Human
![]() |
| Fig 17: Wound on human ankle |
![]() |
| Fig 18:Herbal Bandage tied on the Wound |
![]() |
| Fig 19: Cured wound after 2 days |
This research work has given a new idea in finishing of cotton gauze with herbs of mimosa pudica for antibacterial and wound healing activity.
The above FT-IR and SEM analysis reveals that the herbal extract of mimosa pudica has high antibacterial and wound healing compounds when compared to untreated samples. So it promotes better good healing and reduces the risk of bacterial infection. Since mimosa pudica plant are rich in flavonoids and phenols and abundant availability in many of the countries the scope of implementation and commercialization of herbal extract to impart finishes in textile is will be high and raw material is 100% from natural resources, it is eco-friendly having economic, social and environmental benefits. The treated fabrics were found to be very hygienic with no bacterial infection when compared to conventionally finished fabrics. In the present study, Mimosa Pudica leaves extract possesses a strong wound healing activity against acute and chronic wounds.
Also by testing on Rat (Invitro study) it was found that there was a significant increase in the wound healing activity by this medicated herbal bandage. Treatment of herbal bandage showing reduced days of epithelialization period and more contraction.
From the above findings, it could be concluded that the traditional plants may represent new sources of wound healing with stable, biologically active components that can establish a scientific base for the use of plants in modern medicine. This study has open doors for production of better eco-friendly medically treated Band-Aid.
REFERENCES
- Ajay V. Singh, AnisurRahman, N.V.G. Sudhir Kumar, A.S. Aditi, M. Galluzzi, S. Bovio, S. Barozzi, E. Montani, D. Parazzoli “ Bio-inspired approaches to design smart fabrics” – Article in Press.
- Ambikapathy .V, Gomathi.S, Pannerselvam. A., “ Effect of antifungal activity of some medicinal plants against Pythiumdebaryanum”- Asian Journal of plant science and Research, 2011, 1(3): 131-134
- Baby Joseph, Jency George, Jeevitha Mohan “ Pharmocology and Traditional Uses of Mimosa Pudica”- International Journal of Pharmaceutical Sciences and Drug Research 2013; 5(2); 41-44
- Banupriya.J, Maheshwari.V. “ Comparative study on Antibacterial Finishes by Herbal and Conventional Methods on the Woven Fabrics”- Journal of Textile Science and Engineering 2013 Vol.3
- Banupriya.J, Maheshwari.V, “ Effects of Aromal Finish by Herbal and Conventional Methods of Woven Fabrics”- Journal of Textile Science and Engineering 2013 Vol. 3
- DebasisBhunia and Amal Kumar Mondal, “ Systematic analysis of an Aquatic Medical Plant water Mimosa in Eastern India”- International journal of Life Sciences biotechnology and Pharma Research 2012 vol.1
- Doss.A, Vijayasanthi.M, Parivuguna.V, Anand.S.P, “ Evaluation of Antibacterial Properties of Ethanol and Flavonoids From Mimosa PudicaLinn.andPanicum Maximum Jacq”- Plant Sciences Feed 2011-1(2): 39-44
- GangaiAbirami.S.K, SudhaMani.K, NishaDevi.M, NirmalaDevi.P, “ The Antimicrobial Activity of Mimosa Pudica”- International Journal of Ayurveda and Pharma Research 2012;2(1):105-108
- Gulab Khan Rohela, KiranSaini, Surekha and Christopher.T, “ Screening of secondary Metabolites and Antimicrobial activity of Mimosa Pudica”- Research Journal Of Pharmaceutical, Biological and Chemical Sciences 2011 vol.2 474-479
- Gulzaralam, ManjulPratap Singh, Anita singh, “ Wound Healing Potential of some medical plants”- International Journal of Pharmaceutical Sciences Review and Research 2011 vol.9 136-145
- Hasabo Muhammad Ahmed, Rajendran.R, Balakumar.C, “ Nanoherbal Coating of cotton fabric to enhance antimicrobial durability”- Applied Chemistry 2012
- Ibrahim.D, Muhammad.I, Kanoma.A.I, Shehu.K, Aliero.A.A, Aliyu.R.U, “ Antifungal screening of Mimosa Pudica plant extracts against phytopathogenic fungi”- Open Science of Journal of Bioscience and Bioengineering 2014; 1(1): 1-12
- Joby Jose, SudheeshSudhakaran, Sumesh Kumar, Sony Jayaraman, JayadeviVariyar, “ A Comparative Evaluation of Anticancer Activities of flaconoids Isolated from Mimosa Pudica, Aloe Vera and PhyllanthusNiruri Against Human Breast Carcinoma Cell Line using MTT Assay” – International Journal of Pharmacy and Pharmaceutical Sciences 2014 vol.6
- Krishna Veni, Amsa Mani, “ Preparation and Characterization of Medical Herb GlycyrrhizaGlabra and a study of the Anti-Microbial and Thermal Properties on Cotton” – Journal of Textile and Apparel, Technology and Management 2012 vol.7
- LubnaAzmi, Manish Kumar Singh and Ali Kamal Akhtar, “ Pharmacological and Biological Overview on Mimosa Pudica Linn”- International Journal of Pharmacy and Life Sciences 2011 2(11): 1226-1234
- Mahesh.S, Manjunatha.A.H, VijayaKumar.G, “ Studies on Antimicrobial Textile Finish using Certain Plant Natural Products” – International Conference on Advance in Biotechnology and Pharmaceutical Sciences 2011
- Malone.M, “ Wound-induced hydraulic signals and Stimulus transmission in Mimosa Pudica”- Horiculture Research International, 1994: 49-56
- Manish Pal Singh, Bharghava.S, Bhaduaria.R.S, Sharma.C.S, “ Wound Healing Potential of Alcoholic Extract of Mimosa Pudica Linn. Leaves”- Pharmacologyonline 2010 ;2: 32-38
- MilindPande, AnupamPathak, “ Preliminary Pharmacognostic Evaluations and Phytochemical Studies on Roots of Mimosa Pudica” – International Journal of Pharmaceutical Sciences Review and Research 2010; vol.1
- M L Gulrajini, Deepti Gupta, “ Emerging Techniques for Functional Finishingn of Textiles”- Indian Journal Of Fibre and Textile Research 2011; vol.36, 388-397
- M P Sathinarayanan, Bhat.N.V, Kokate.S.S, Walnuj.V.E, “ Antibacterial Finish for cotton fabric from herbal products” – Indian Journal of Fiber and Textile Research 2010; vol.35: 50-58
- Naveen Alasyam, Mannala Sunil, Jayashree.T, VinayKumar.K, Nagesh and NarapoguVenkatanarayana, “ Evaluation of Anticonvulsant activity of alcoholic extract of Mimosa Pudica in Swiss albino rats”- Journal of Chemical and Pharmaceutical Research 2014 , 6(4): 1175-1179
- Nilesh Kumar, PalwinderKaur, Kuntal Das, SudiptaChakroborty, “Mimosa Pudica L. A Sentitive Plant” – International Journal of Pharmacy and Pharmaceutical Sciences, 2009. Vol.1
- PalwinderKaur, Nilesh Kumar, Shivananda.T.N, GagandeepKaur, “ Phytochemical Screening and antimicrobial activity of the plant extracts of Mimosa Pudica L. against selected microbes”- Journal Of Medical Plants Research, 2011, vol.5(22)
- Parikshit.A, Champanerkar, Vikas.V, Vaidya, SunithaShailajan, Sasikumar.N, Menon, “ A sensitive, rapid and validated liquid chromatography-tandem mass spectrometry method for determination of Mimosine in Mimosa Pudica”- Natural Science 2010, vol.2; 713-717
- Pham Ngoc Anh Thu, PhanThanh Long and Dong ThiAnh Dao, “ Study on Extraction of Mimosine From Sensitive Plant for Drinks Production’- Food Technology
- RajeshwariSaraswat and RaghunathPokharkar, “ GCMS Studies of Mimosa Pudica”- International Journal of Pharm Tech Research 2012; vol.4, 93-98
- RekhaRajendran, S.Hemalatha, K. Akasakalai, Madhukrishna, BhavanSohil, Vittal and R. MeenakshiSundaram, “ Hepatoprotective activity of Mimosa Pudica leaves against Carbontetrachloride induced toxicity”- Journal of Natural Products, 2009; vol.2 : 116-122
- Ramya.S, Aluguchamy.N, Maruthappan.VM, Sivaperumal.R, Sivalingam.M, Krishnan.A, Govindaraju.V, Kannan.K, JayaKumararaj.R, “ Wound Healing Ethnomedicinal Plants Popular among the Malayali Tribes in Vattal Hills, Dharmapuri, TN, India”- 2009; 1257-1271
- Renu Singh, Yogesh, Jasrai.T, “ Mimosa hamata, a plant with anti-pathogenic properties”- Science Research publisher 2012; vol.2